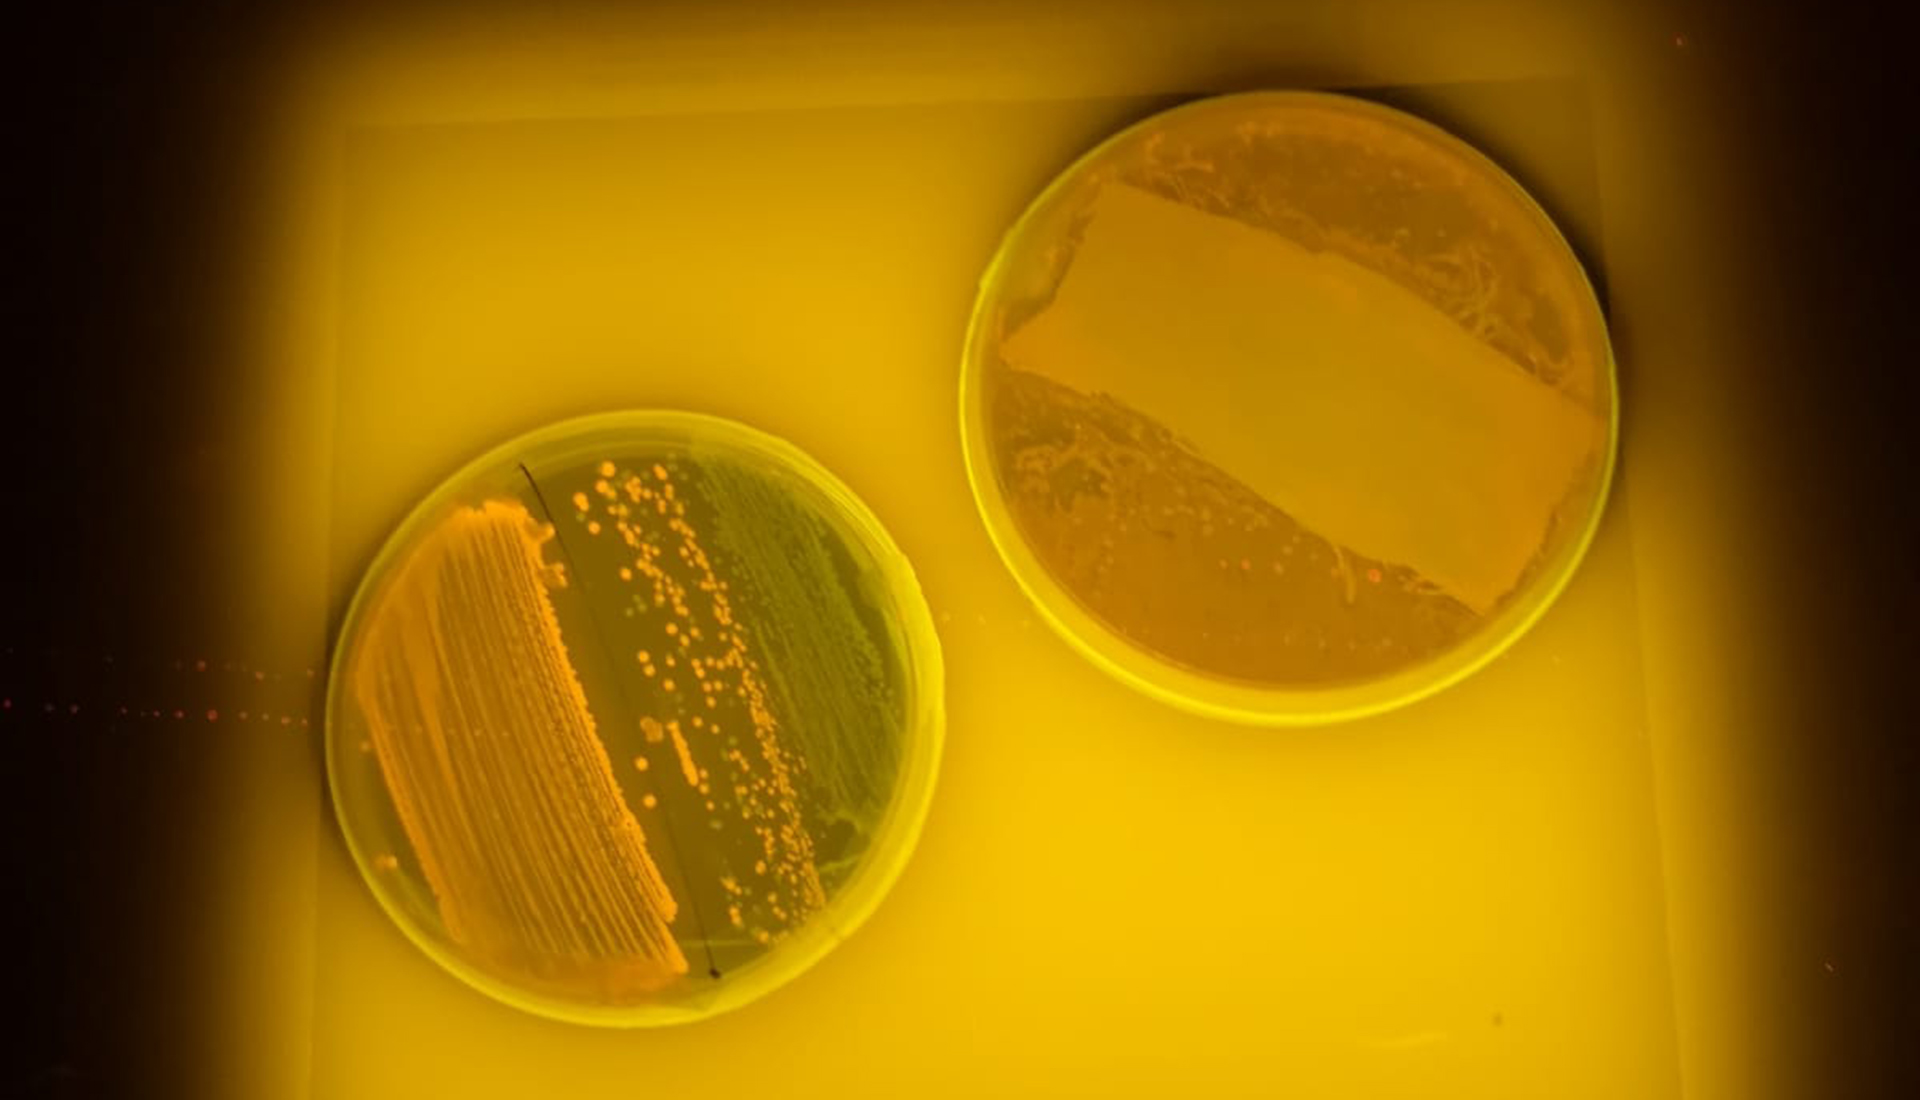

Өвчин үүсгэгч нянгуудыг устгадаг будаг бүтээжээ
Их Британийн химич эрдэмтэд эпоксидын давирхай болон хлоргексидин ашиглан гэдэсний савханцар, стафилококк болон өвчин үүсгэгч бусад нян бактерийг удаан хугацааны туршид устгах чадвартай будаг бүтээсэн байна.
Түүнийг хэрэглэх нь эмнэлэг хийгээд олон нийтийн өрөө тасалгаанууд дахь устгалд өртдөггүй нянгуудын тархалтыг сааруулах боломж олгох юм гэж Ноттингемийн их сургуулийн хэвлэлийн албанаас мэдээлжээ.
“Олон нийтийн газруудад өргөн хэрэглэдэг хуванцар болон металл гадаргуунууд нь өвчин үүсгэгч микробууд үүрлэх нөөцлүүр болдог ба халдваргүйжүүлэлт тогтмол хийсэн ч ийм гадаргуунууд нь антибиотикуудад тэсвэртэй ген тархахад тус дөхөм үзүүлдэг. Ийм учраас өвчин үүсгэгч нянгууд тархаж, өвчтөний бие махбодод орохоос сэрэмжлэх микробын эсрэг бүрхүүл бүтээх нь бидний хувьд маш чухал байсан юм” гэж Ноттингемийн их сургуулийн доцент Фелисити де Коган онцолсон байна.
Биохимичид болон материал судлаачид сүүлийн жилүүдэд ийм хэд хэдэн бүрхүүл бүтээсэн боловч тэдгээрийн олонхи нь хурдан элэгддэг юм уу өндөр өртөгтэй урвалжууд, түрхэх арга шаарддаг тул нян халдварласан байх магадлалтай гадаргууд хүмүүс байнга хүрч байдаг олон нийтийн газруудад өргөн хэрэглэх боломжгүй байдаг ажээ.
Иймд Их Британийн химичид өргөн тархсан олон тооны будаг, лак үйлдвэрлэхэд ашигладаг микробын эсрэг хамгийн хямд бөгөөд энгийн бодисуудын нэг болох глюконат хлоргексидиныг эпоксидын давирхайд шингээхийг эрмэлзсэн байна. Глюконат хлоргексидины молекулуудыг будгийн өнгөн давхаргад байнга байж, нянгуудтай харьцдаг байхаар эпоксидын давирхайд шингээх боломжтой гэдгийг эрдэмтдийн явуулсан олон туршилт харуулжээ.
Судлаачдын бүтээсэн будгийг өвчин үүсгэгч хэлбэрийн гэдэсний савханцар, стафилококк болон Candida albicans мөөгөнцөр дээр туршиж үзэхэд хлоргексидин нэмсэн эпоксидын будаг нь эдгээр гурван төрлийн өвчин үүсгэгчийг гурван сар гаруй хугацааны туршид хурдан устгаж байжээ.



Сэтгэгдэл ( 0 )